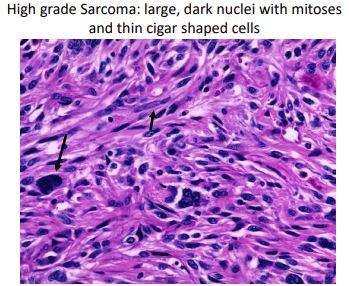

osteoid osteoma
age? what do nsaids inhibit?
what will you see in the spine? Metaphysis?
histology. whats the best imaging? treatment

Biopsy Principles
What type of incision?
Proximal Humerus biopsy, what compartment?
In general go for ____, and avoid ___
core needle biopsy higher risk of ? than incisional biopsy

radiation
Pre-op xrt ?
post op xrt ?
convential radition is?
What’s proton beam therapy?
risk of cryotherapy?

genetics
MDM2 amplification
t(12;16)
t(X;18), SYT-SSX
t(11;22), EWS-FLI
t(2;13), PAX-FKHR
t(12;22), EWS-ATF
t(9;22), EWS-CHN
Infantile fibrosarcoma?
How to determine translocation?

osteoblastoma
age?
how is it different from OO?
size of lesion?
histology?
tx?

Osteiod Osteoma vs Osteoblastoma
histology?
treatment?
size?

osteosarcoma
age?
location?
xray and histology?
testable items?
Treatment: chemo + surgery
no genetic translocation but associated with alterations in Rb and p53 genes
IHC: SATB2 new differentiator

osteosarcoma surface lesions
Parosteal “PAR” =
Periosteal

ParostealPAR= stuck on bone
low grade, wide excision, good prognosis.
PERIosteal = high grade, sunburst surface lesion, eccentric

osteosarcomas
Conventional vs Par vs Peri on imaging and histology


parosteal vs HO vs MHE?
How to spot the difference on CT?

telengiectatic OSA
what will you see on histology? How to differentiate with ABC?

Paget’s disease
what cancer are they at risk for?
Prognosis?
Age?

treatments for
Parosteal osteosarcoma vs Periosteal osteosarcoma vs all other osteosarcomas?
key test item
Parosteal = wide resection
PERI and All other Osteosarcoma get chemo and surgery
chrondogenic lesions
name the 5?

Soft tissue lesions
what size cm is concerning? (size in hands ant feet)
Don’t be fooled by Soft Tissue Sarcomas because they present as?
* ALL Require appropriate evaluation before
resection
* * > 5 cm (1.5 cm hands/ feet) needs 3-D imaging (CT/MRI)
* FNA/Biopsy
- Soft Tissue Sarcomas – DONT BE FOOLED!
(STEM)
– Painless
– Insidious onset
whoops surgery: unplanned excision
What do you do if you excise a mass and it comes back as a sarcoma?

unplanned excision
why should you be aware of “atraumatic hematoma”!!, what should you do before wash out?
- Imaging of sarcoma with hemorrhage and
hematoma appear the same - BIOPSY before washout
Soft tissue sarcomas
size to be worried about?
how to stage?
better/worse prognosis indicators?
synovial sarcoma: genetics?

STS
growth characteristics?
histology?

STS
Most common STS?

STS
Predisposing factors?

STS imaging
MRI will show ?
What’s the exception

Most Common STS Pathology?


Synovial sarcoma
tx?
presentation?
genetic factos to know?
how does it look on histology?

tx: radiation therapy and surgery, some benefit to chemo (exception to the rule for STS)
Grow rapidly
t(x:18)
SYT/ssx1 & SYT/SSX2 fusion transcripts

































































































